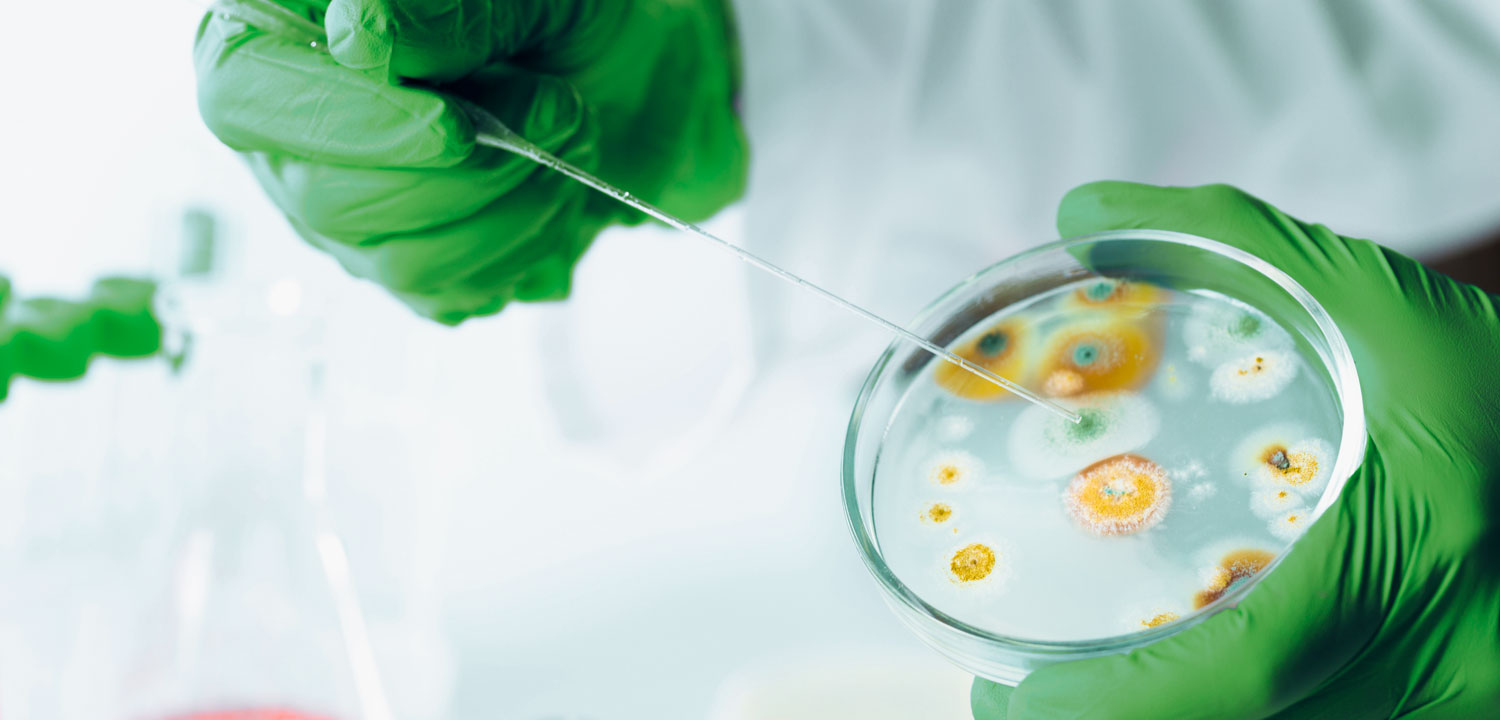

servicios
Contamos con los estudios más solicitados para agricultura, y todo lo que necesitas para operar ante la ley.
Servicios
Estudios de laboratorio

Determinación de Listeria monocytogenes
NOM-21O-SSA1-2014

Determinación de Salmonella spp.
NOM-210-SSA1-2014

Determinación de S. aureus
NOM-210-SSA1-2014

Determinación de Bacterias Mesofílicas Aerobias
NOM-210-SSA1-2014

Determinación de
Mohos y levaduras
NOM-111-SSA1-1994

Determinación de Escherichia coli (E. coli).
NOM-210-SSA1-2014

Fisicoquímicos de
aguas y alimentos
NOM-127-SSA1-2021
NOM-251-SSA1-2009
NOM-201-SSA1-2015

Indicadores en Producto Terminado y Materia prima
NOM-092-SSA1-1994
NOM-210-SSA1-2014
NOM-111-SSA1-1994

multiresiduos de pesticidas y metales pesados
Otros servicios
Microbiológicos
Control microbiológico de Agua

Control microbiológico de superficies vivas e inertes

Control microbiológico de ambiente
Contáctanos
Habla con nosotros
¿Necesitas una Cotización? ¿Tienes dudas acerca de alguno de nuestros servicios? ¿No sabes que estudios requieres para cierto permiso?
llámanos
351 137 6675
